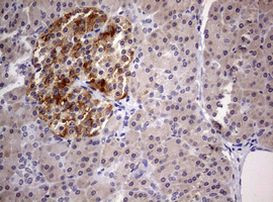
DICER1 Antibody in Immunohistochemistry (Paraffin) (IHC (P))

Search
OriGene
DICER1 Monoclonal Antibody (OTI1D9), TrueMAB™
{{$productOrderCtrl.translations['antibody.pdp.commerceCard.promotion.promotions']}}
{{$productOrderCtrl.translations['antibody.pdp.commerceCard.promotion.viewpromo']}}
{{$productOrderCtrl.translations['antibody.pdp.commerceCard.promotion.promocode']}}: {{promo.promoCode}} {{promo.promoTitle}} {{promo.promoDescription}}. {{$productOrderCtrl.translations['antibody.pdp.commerceCard.promotion.learnmore']}}
产品信息
TA801633
种属反应
宿主/亚型
分类
类型
克隆号
抗原
偶联物
形式
浓度
纯化类型
保存液
内含物
保存条件
运输条件
靶标信息
Dicer is a double-stranded RNA (dsRNA) endoribonuclease playing a central role in short dsRNA-mediated post-transcriptional gene silencing. It cleaves naturally occurring long dsRNAs and short hairpin pre-microRNAs (miRNA) into fragments of twenty-one to twenty-three nucleotides with 3' overhang of two nucleotides, producing respectively short interfering RNAs (siRNA) and mature microRNAs. SiRNAs and miRNAs serve as guide to direct the RNA-induced silencing complex (RISC) to complementary RNAs to degrade them or prevent their translation. Gene silencing mediated by siRNAs, also called RNA interference, controls the elimination of transcripts from mobile and repetitive DNA elements of the genome but also the degradation of exogenous RNA of viral origin for instance. The miRNA pathway on the other side is a means to specifically regulate the expression of target genes.
仅用于科研。不用于诊断过程。未经明确授权不得转售。
篇参考文献 (0)
生物信息学
蛋白别名: DCR; DCR-1; dicer 1 ribonuclease III; dicer 1, double-stranded RNA-specific endoribonuclease; dicer 1, ribonuclease type III; Dicer1, Dcr-1 homolog; Endoribonuclease Dicer; Helicase MOI; Helicase with RNase motif; helicase-moi
基因别名: DCR1; DICER; DICER1; Dicer1e; HERNA; K12H4.8-LIKE; KIAA0928; MNG1; RMSE2
UniProt ID: (Human) Q9UPY3
Entrez Gene ID: (Human) 23405